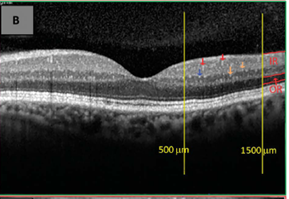

Advances in
eISSN: 2377-4290


Mini Review Volume 12 Issue 2
Professor of ophthalmology, Ain Shams University, Vitreoretinal surgery consultant at Dhahran Eye Specialist Hospital, Egypt
Correspondence: Ahmed Darwish, Professor of ophthalmology, Ain Shams University, Vitreoretinal surgery consultant at Dhahran Eye Specialist Hospital, KSA, Egypt, Tel 00966568568290
Received: July 16, 2022 | Published: July 29, 2022
Citation: Darwish A. The significance of hyper-reflective spots in OCT imaging in retinal diseases. Adv Ophthalmol Vis Syst. 2022;12(2):49-50. DOI: 10.15406/aovs.2022.12.00417
Hyperreflective spots (HRS), also named hyperreflective foci or hyperreflective dots in the literature1-6 are abnormal hyperreflective elements detected by OCT imaging.7 Those spots are reported to be in the outer retinal layers in neovascular age related macular degeneration (nAMD), papilledema, branch retinal vein occlusion (BRVO) , central retinal artery occlusion(CRAO),central serous retinopathy (CSCR) choroidal folds and Best disease. When located in the outer retina the spots are more typically located around pockets of fluid and sensory neural detachment areas. The spots may be also concentrated in the middle retinal layers in commotio retinae cases 7 . Some authors reported the distribution of HRSs in all retinal layers in retinal vein occlusion.8
It was hypothized that HRSs represent focal accumulation of pigment or lipofuscin granules, this hypothesis was negated by the use of blue light fundus photography and fundus autofluorescence because of the absence of hyperautoflourescence characteristic for lipofuscin and melanolipofuscin granules.9,10
In age related macular degeneration (AMD) and other degenerative retinal diseases (including diabetic retinopathy) it was postulated by several authors that the origin of HRSs is from activated microglial cells.10-12 Microglial cells when present in the resting state have small cell bodies and lengthy ramifications and are located in the inner retinal layers.13 On activation, the size of the cell body increases and the ramifications decrease and the cells tend to aggregate.14 Activation of microglial cells is usually associated with microglial pervasculitis and the release of inflammatory mediators as VEGF and others which extend the inflammatory response from the inner retina to the entire retina causing an increase in vascular permeability (breakdown of the blood retinal barrier) and neuronal damage.15-17 The increase in the level of CD14 (an inflammatory biomarker only expressed in microglia and macrophages) strongly supports this hypothesis.18
In the case of choroidal folds and commotio retinae, both of which may have an inflammatory pathogenesis, the HRSs may be inflammatory cells. On the other hand, diseases without an inflammatory component as central serous retinopathy or Best disease, the HRSs may be outer segments of damaged photoreceptors engulfed by activated microglial cells or macrophages. In neurological and vascular diseases as papilledema, branch or central retinal artery occlusions, the cause of HRSs may be either photoreceptor damage or ischemia of the inner retinal layers.19
Hyperreflective spots differ from hard exudates and microaneurysms in the fact that they do not cause back shadowing on OCT imaging unlike the other 2 lesions.20 HRSs are also smaller in size (<30u) as compared to the other 2 lesions being >30u and have moderate reflectivity (similar to the nerve fiber layer) similar to microaneurysms but different from hard exudates which have higher reflectivity (similar to RPE-Bruch membrane complex).21-23 HRSs can be detected in any of the inner or outer retinal layers unlike hard exudates which are usually present in the outer retinal layers and microaneurysms which are located in the inner retinal layers.23 Because the more accepted pathogenesis of HRSs is microglial activation with subsequent inflammatory response, (Figure 1 & 3) the effect of intravitreal dexamethone implants (a potent anti-inflammatory agent) and intravitreal anti VEGF agents (a less potent anti-inflammatory agent but with an antiactivated microglial activity) on HRSs and other parameters as visual acuity and central macular thickness was evaluated by several authors.24,25

Figure 1 HRS, note their distribution in all retinal layers, moderate reflectivity, no back shadowing.23

Figure 2 Hard exudates, note their distribution in the outer retinal layers, High reflectivity and the presence of back shadowing.23
Figure 3 Red arrows indicate retinal microaneurysms from the superficial retinal capillaries located at the inner retina with moderate reflectivity and presence of back shadowing.23
It was observed in several studies that eyes with treatment naive diabetic macular edema (in which we expect a significant role of inflammation) that were treated with either intravitreal anti-VEGF or dexamethasone implant or focal laser, the treatment associated decrease in number of HRSs was positively correlated with an improvement in visual acuity and a decrease in central retinal thickness as measured by OCT.26-33 In refractory diabetic macular edema, however, the pathogenesis is multifactorial and therefore the latter correlation was not observed.34-36
Few studies compared the resolution of HRSs after dexamethasone implant treatment as compared to anti VEGF treatment, 2 studies found a similar response while 3 studies found a better response with dexamethasone implants.37
In conclusion, the clinical significance of hyperreflective spots is that HRSs appear to be a reliable biomarker in the evaluation of the treatment response to anti VEGF, steroid implants and focal laser therapy in diabetic macular edema (the commonest disease studied in relation to HRSs so far). The recognition of HRSs and their differentiation from similar lesions on OCT examination will help in the future evaluation of the inflammatory component in several retinal vascular and degenerative diseases and their response to treatment.
None.
None.

©2022 Darwish. This is an open access article distributed under the terms of the, which permits unrestricted use, distribution, and build upon your work non-commercially.